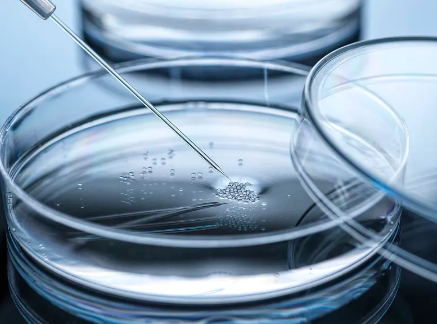
image.png

湖北幹細胞機構一覽,哪家口碑比較好?
2024-10-22 11:00:40 來源: 小編 咨詢醫生
幹細胞研究作爲現**物科技的前沿領域,吸引了衆多醫療機構和研究機構的關注。在湖北地區,也有不少優秀的幹細胞機構,本文将爲您詳細介紹湖北地區的幹細胞機構,并探讨哪家機構的口碑最佳。
一、湖北幹細胞機構概況
1.武漢大學中南醫院幹細胞研究中心
武漢大學中南醫院幹細胞研究中心成立于2006年,是我國較早從事幹細胞研究與應用的機構之一。中心擁有一支專業的科研團隊,開展了一系列關于幹細胞的基礎研究與臨床應用研究。
2.湖北省人民醫院幹細胞治療中心
湖北省人民醫院幹細胞治療中心成立于2010年,是湖北省内較早開展幹細胞臨床治療的醫療機構。中心擁有一流的實驗室設備和專業的技術團隊,爲患者提供高質量的幹細胞治療服務。
3.華中科技大學同濟醫學院附屬協和醫院幹細胞治療中心
華中科技大學同濟醫學院附屬協和醫院幹細胞治療中心成立于2012年,是一家集科研、臨床、教學于一體的綜合性幹細胞治療機構。中心以神經系統疾病、心血管系統疾病和免疫系統疾病等領域爲研究方向,取得了顯著成果。
4.武漢科技大學同濟醫學院附屬協和醫院幹細胞研究中心
武漢科技大學同濟醫學院附屬協和醫院幹細胞研究中心成立于2017年,緻力于幹細胞的基礎研究和臨床應用。中心擁有一支高水平的科研團隊,爲患者提供專業的幹細胞治療服務。
二、哪家湖北幹細胞機構口碑比較好?
綜合以上四家湖北幹細胞機構的成立時間、科研實力、治療項目、設備水平等多方面因素,華中科技大學同濟醫學院附屬協和醫院幹細胞治療中心在湖北地區的口碑較好。
1.成立時間較早:華中科技大學同濟醫學院附屬協和醫院幹細胞治療中心成立時間較早,積累了豐富的臨床經驗。
2.科研實力強大:中心擁有一支高水平的科研團隊,多項研究成果在國際上發表。
3.治療項目豐富:中心涵蓋了神經系統疾病、心血管系統疾病、免疫系統疾病等多個領域的幹細胞治療項目。
4.設備水平一流:中心擁有一流的實驗室設備和專業的技術團隊,爲患者提供高質量的幹細胞治療服務。
總結:湖北地區的幹細胞機構在不斷發展,爲廣大患者提供了更多治療選擇。華中科技大學同濟醫學院附屬協和醫院幹細胞治療中心在口碑、科研實力、治療項目等方面具有較大優勢,是湖北地區口碑比較好的幹細胞機構之一。在選擇幹細胞治療時,患者可根據自身需求,綜合考慮各家機構的實力,選擇最适合自己的治療方案。
-
上一頁: 甯波幹細胞作用機制解析,真的可靠嗎?
- 2024-10-31北京哪家幹細胞臨床醫院最受歡迎?
- 2024-10-25濰坊哪家幹細胞醫院口碑最佳?
- 2024-09-28山西的幹細胞重組培訓機構哪家強?
- 2024-10-22武漢幹細胞治療招募機構有哪些?治療條件是什麽?
- 2024-12-07海南幹細胞醫院哪家好呢,有什麽技術優勢
- 2024-10-21台州哪家幹細胞醫院功效比較好?患者評價如何?
- 2024-08-23幹細胞療法高血脂能治好嗎,詳解其原理機制
- 2024-09-30常德幹細胞捐贈機構有哪些,如何辨别合法與非法機構
- 2024-08-26幹細胞移植有什麽作用,詳解其治療效果與應用領域
- 2024-10-12幹細胞治療與未來治療方法相比哪個更好?前景如何?
- 2024-09-16湖南生物幹細胞存儲公司排名榜單公布
- 2024-08-12幹細胞向成體細胞分化的過程
- 2024-09-03紫草幹細胞的作用與用途是什麽
- 2024-09-09深圳儲存幹細胞費用,多少錢一年
- 2024-09-27貝拉國際醫院幹細胞怎麽樣
- 2024-09-27幹細胞注射真的有效果嗎,哪些因素影響成效
- 2024-09-20福州總醫院幹細胞移植費用多少錢
- 2024-08-21子宮内膜幹細胞移植費用及預期效果
